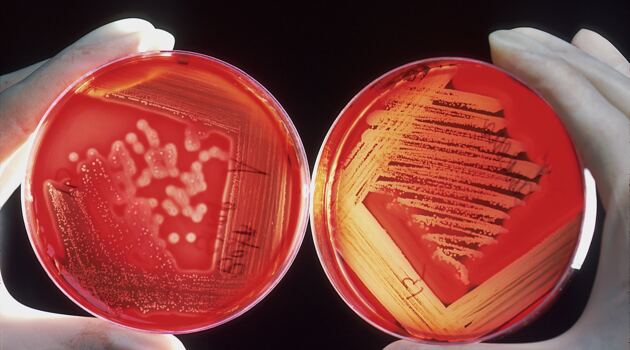

Все материалы за 29 августа 2023
Август
пн
вт
ср
чт
пт
сб
вс
Новости медицины29 августа 2023

Новости29 августа 2023

Новости медицины29 августа 2023

Новости29 августа 20231

Новости29 августа 2023

Новости ЗОЖ29 августа 2023

Новости29 августа 2023
Новости партнеров